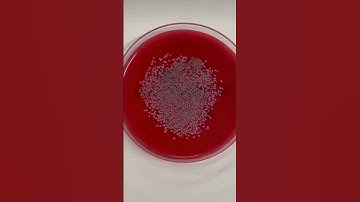
Laboratory#laboratory #science #laboratorytechniques #labtechnition #science #lab #biotechnology #yt

⬇ DOWNLOAD NOW
Kalau muncul iklan pop-up, tutup lalu klik tombol kembali
Download lagu Good Laboratory Practices Every Biotech Student MUST Know | GLP Rules for Lab Safety #biotech secara gratis hanya untuk keperluan promosi. Dukung artis favorit kamu dengan membeli musik original di iTunes atau platform resmi lainnya.
 Good Laboratory Practices in Microbiology: 10 Essential Good Lab Practices for Success| GPL
Good Laboratory Practices in Microbiology: 10 Essential Good Lab Practices for Success| GPL
 Introduction to Biotechnology | Don't Memorise
Introduction to Biotechnology | Don't Memorise
Laboratory#laboratory #science #laboratorytechniques #labtechnition #science #lab #biotechnology #yt
Laboratory#laboratory #science #laboratorytechniques #labtechnition #science #lab #biotechnology #yt
 Lab safety Rules | Biotech Era |
Lab safety Rules | Biotech Era |
 Biotechnologist Salary in Korea #indianinkorea #southkorea #jobs #shorts
Biotechnologist Salary in Korea #indianinkorea #southkorea #jobs #shorts
 Every biotechnology student can relate📈💔#trendingshorts #youtubeshorts #medicalcollege #biotech
Every biotechnology student can relate📈💔#trendingshorts #youtubeshorts #medicalcollege #biotech
 Embedding is my favourite bench #laboratory #science #laboratorytechniques #lab #biotechnology #yt
Embedding is my favourite bench #laboratory #science #laboratorytechniques #lab #biotechnology #yt
 What is Biotechnology? 🧬 #biotech #science #scientist #stem #dothingsyoudontwanttodo #research
What is Biotechnology? 🧬 #biotech #science #scientist #stem #dothingsyoudontwanttodo #research